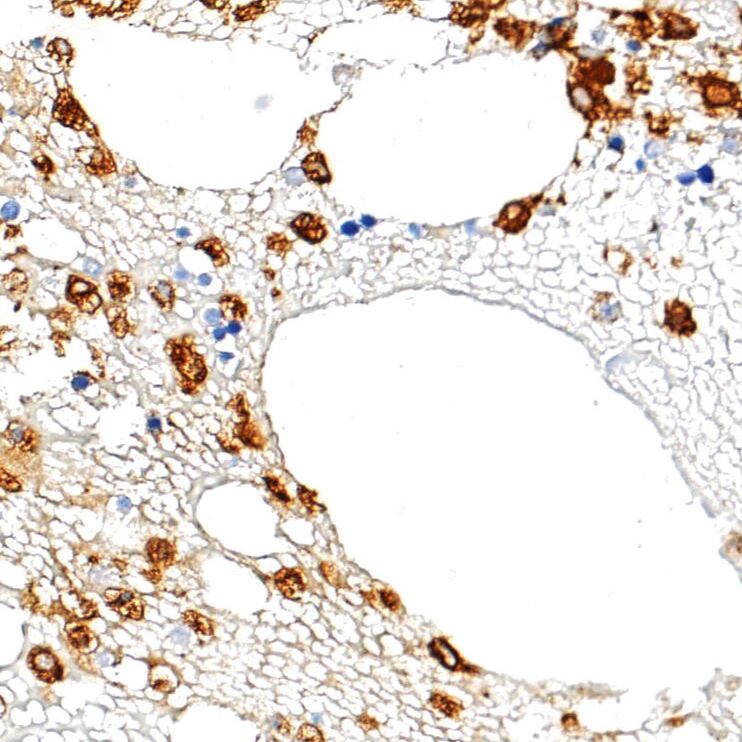
产品封面图

相关产品推荐更多 >
万千商家帮你免费找货
0 人在求购买到急需产品
- 详细信息
- 技术资料
- 供应商:
北京云肽生物科技有限公司
- 库存:
99
中杉金桥 ZA-0197 Myeloperoxidase 抗体试剂 (免疫组织化学)
我们北京云肽生物科技有限公司作为 中杉金桥 公司的特约经销商为客户提供,正规进口,保证原装正品,货期稳定,折扣好的服务标准。
北京中杉金桥生物技术有限公司建有专业的免疫组化实验室、分子病理实验室,2016年成为中国医学装备协会病理装备分会 shou jia 认证的免疫组化专项培训基地和分子病理培训基地。长期以来,公司积极参加病理行业协(学)会、认真落实行业政策,成为具有行业责任感和社会责任感的企业。公司获得中国医疗器械行业协会病理专业委员会、中国医学装备协会病理装备分会和北京肿瘤病理精准诊断研究会常务理事会员单位。
未来,我们将继续弘扬“立德、敬业”的企业精神,以高度的社会责任感和使命感,开拓创新、锐意进取。坚持以科学发展观为指导,以解决客户需求为目标,全心全意为用户提供 zui you 质的产品和服务。
中杉金桥 ZA-0197 Myeloperoxidase 抗体试剂 (免疫组织化学),产品简介:
产品品牌:中杉金桥
产品货号:ZA-0197
产品名称:Myeloperoxidase 抗体试剂 (免疫组织化学)
产品规格:1.5ml
中杉金桥 ZA-0197 Myeloperoxidase 抗体试剂 (免疫组织化学),产品说明:
分类: 常用抗体
子分类: 常用抗体
克隆号: 兔多克隆
推荐效价: 原液使用前应稀释(稀释比例请参见产品标签);工作液不必稀释,直接滴加使用。
应用: Myeloperoxidase(MPO)基因位于17号染色体,与人甲状腺过氧化物酶具有同源性。髓过氧化物酶抗体是骨髓细胞的特异性标记。在外周血涂片中,粒细胞呈强阳性反应,单核细胞呈弱阳性反应,而其它细胞不反应;在骨髓涂片中,用于标记粒系细胞。MPO在急性骨髓性白血病、粒细胞性白血病、单核细胞性白血病、成髓细胞瘤和其它造血系统疾病的成髓细胞和未成熟骨髓细胞中表达。在某些肺癌和卵巢癌也可见表达。用于淋巴造血系统疾病的研究
阳性部位: 细胞质
阳性对照: 骨髓穿刺组织
Symbol: Myeloperoxidase
产品订购信息:
ZA-0197 中杉金桥 Myeloperoxidase 抗体试剂 (免疫组织化学) 1.5ml
风险提示:丁香通仅作为第三方平台,为商家信息发布提供平台空间。用户咨询产品时请注意保护个人信息及财产安全,合理判断,谨慎选购商品,商家和用户对交易行为负责。对于医疗器械类产品,请先查证核实企业经营资质和医疗器械产品注册证情况。
技术资料暂无技术资料 索取技术资料
中杉金桥 ZA-0197 Myeloperoxidase 抗体试剂 (免疫组织化学)
询价